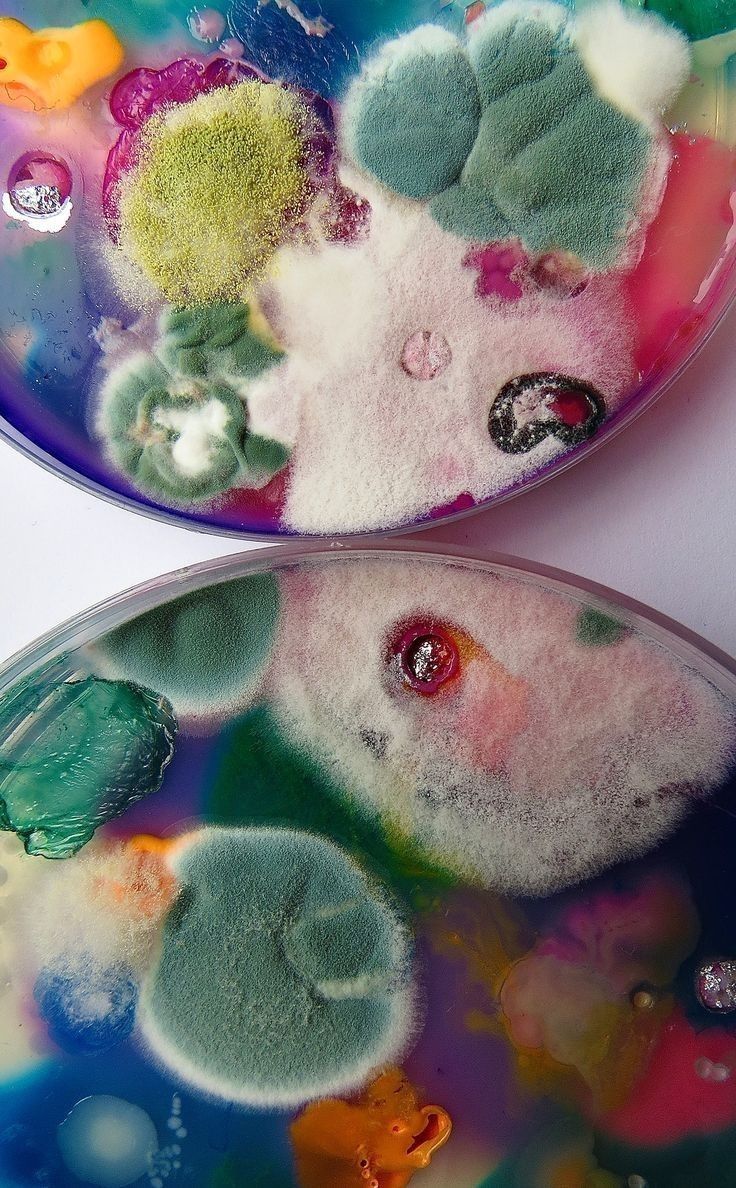

“매일 아침, 눈이 가렵고 코가 막혀요..”
지긋지긋한 콧물·재채기, 혹시 곰팡이 때문은 아닐까요?
“알레르기 검사했는데 집먼지진드기, 꽃가루는 아닌데 계속 증상이 심해요.”
“아이 비염이 환절기마다 악화되는데, 이게 곰팡이랑 관련 있나요?”
“곰팡이 안 보이는데도 알레르기 증상이 계속돼요.”
이런 경험 있으신가요?
많은 분들이 곰팡이 알레르기를 단순한 ‘곰팡이 곰팡이’ 문제가 아닌
내 몸의 면역 반응과 연결된 알레르기 질환임을 인식하지 못합니다.
보이지 않는 곰팡이균 포자,
그것이야말로 가족의 호흡기 건강을 위협하는 진짜 알레르겐(Allergen)일 수 있습니다.
오늘 포스팅에서는
1.곰팡이 알레르기의 증상과 작동 원리
2.국내외 전문가 연구 기반의 알레르기 메커니즘
3.누구나 실천할 수 있는 예방 솔루션
을 체계적으로 소개드립니다.
곰팡이 알레르기란?
곰팡이 알레르기(Mold Allergy)는
곰팡이의 포자(Spores)나 휘발성 유기화합물(VOCs)에 노출된 몸이
비정상적인 면역 반응을 보이는 현상입니다.
곰팡이는 눈에 보이는 ‘덩어리’보다
보이지 않는 미세한 포자 형태로 훨씬 더 자주 우리 몸에 들어옵니다.
이 포자들이 코, 기관지, 폐 등 호흡기를 자극하며
비염, 기관지염, 천식, 두드러기 등 다양한 증상을 유발합니다.
출처 - 미국 알레르기·천식·면역학회 (AAAAI)
“곰팡이 알레르기는 공기 중 포자 노출이 가장 큰 원인이며, 폐로 직접 침투해 증상을 악화시킨다.”
곰팡이 알레르기의 주요 증상 정리
곰팡이 알레르기는 일반 감기와 혼동되기 쉬우며,
증상이 ‘계속 반복된다’는 점이 특징입니다.
| 증상 | 설명 |
| 반복되는 재채기·콧물 | 계절과 관계없이 주기적 발생 |
| 코막힘, 두통 | 실내 습도 높을 때 악화됨 |
| 눈 가려움, 충혈 | 결막염 유사 증상, 아침에 심함 |
| 숨쉬기 불편, 천명음 | 특히 천식환자 악화 요인 |
| 만성피로, 수면장애 | 지속적 알레르기 반응으로 피로 누적 |
| 피부 발진,두드러기 | 일부 접촉성 곰팡이균 노출 시 발생 |
국내외 논문으로 본 곰팡이 알레르기의 심각성
대한의학회 논문 (2022)
“환절기 곰팡이 포자 농도 증가 시, 아동 비염·아토피 환자 수가 통계적으로 유의하게 증가했다.”
World Allergy Organization (WAO) 보고서 (2020)
“곰팡이 알레르기는 전 세계 알레르기 질환자의 20~30%가 겪고 있으며, 주거환경의 습도와 곰팡이 방치가 주요 원인이다.”
서울대병원 환경의학센터
“환기 부족, 결로 발생 구역에서 채취된 공기에서 곰팡이균 농도가 5배 이상 높았으며, 알레르기 지표 수치와 직접 연관되었다.”
곰팡이 알레르기는 단순 ‘불쾌함’이 아니라
만성 질환으로 이어질 수 있는 호흡기·면역계 질병입니다.
곰팡이 알레르기 예방을 위한 실천 방안
1.실내 습도 조절 (45~55%)
습도가 60%를 넘으면 곰팡이균은 쉽게 증식할 수 있습니다.
>제습기 사용 / 수건 건조 최소화 / 젖은 빨래 방치 금지
[출처] WHO Indoor Air Guidelines
“습도 60% 이상에서 곰팡이 포자 증식률은 2~3배 증가”
“환기 부족, 결로 발생 구역에서 채취된 공기에서 곰팡이균 농도가 5배 이상 높았으며, 알레르기 지표 수치와 직접 연관되었다.”
곰팡이 알레르기는 단순 ‘불쾌함’이 아니라
만성 질환으로 이어질 수 있는 호흡기,면역계 질병입니다.
2.정기적 환기 및 결로 제거
곰팡이 알레르기의 주요 원인 중 하나는
결로로 인한 숨은 곰팡이 서식지입니다.
새벽아침 - 510분씩 환기 필수
욕실,창틀·가구 뒤 결로 수시 확인
습기 많은 벽은 ‘제습제’와 함께 사용
3.공기 중 곰팡이균 차단
HEPA 필터 공기청정기
활성탄 필터 > 곰팡이 냄새,VOC까지 제거
UV-C 살균램프 > 공기 중 포자 살균 보조
4.곰팡이균 제거 시공 + 단열 시공
단순 곰팡이 제거제로 닦는 건 겉모습만 지우는 것에 불과합니다.
벽지 속,단열재 틈,실리콘 내부까지 포자 박멸 필요
열교차 구간 단열 보강 > 결로 자체를 차단
5.침구·커튼 등 패브릭 관리
곰팡이균은 푹신한 섬유 속에 잘 정착합니다.
침구류 주 1회 고온세탁
매트리스, 베개 자외선 건조기 활용
커튼, 러그는 계절별 교체 및 세탁
곰팡이는 눈에 보일 때보다, ‘냄새조차 안 날 때’가 더 위험합니다
곰팡이 알레르기는 눈에 보이는 곰팡이가 아닌
공기 중 보이지 않는 곰팡이균 포자에 의해 발생합니다.
그 증상은 비염처럼 시작하지만,
천식,피부질환,면역기능 저하 등으로 전신 건강에 영향을 줍니다.
“곰팡이 없어 보이는데 왜 아프지?”
그 질문의 답이 오늘 이 글 안에 있습니다.
이제 닦는 것이 아니라,
곰팡이균을 ‘환경적으로 차단하는 전략’이 필요한 시대입니다.
다음 포스팅은 어린이와 노인에게 특히 위험한 곰팡이에 대한
글을 준비하겠습니다:)
'곰팡이' 카테고리의 다른 글
| 곰팡이 피부염과 무좀, 같은 곰팡이지만 전혀 다른 질병입니다 (0) | 2025.07.05 |
|---|---|
| 곰팡이와 피부 트러블, 말라세지아 모낭염이란? (0) | 2025.07.04 |
| 곰팡이 제거 후에도 냄새가 계속 나는 이유! (0) | 2025.07.03 |
| 어린이와 노인에게 특히 위험한 곰팡이 (1) | 2025.07.03 |
| 곰팡이균은 왜 환절기에 더 잘 생길까? (0) | 2025.07.02 |
| 곰팡이와 곰팡이균은 다를까? (0) | 2025.07.01 |
| HEPA필터로 곰팡이 포자 차단 가능할까? (0) | 2025.07.01 |
| 곰팡이 포자, 공기 중에서 얼마나 위험할까? (0) | 2025.07.01 |